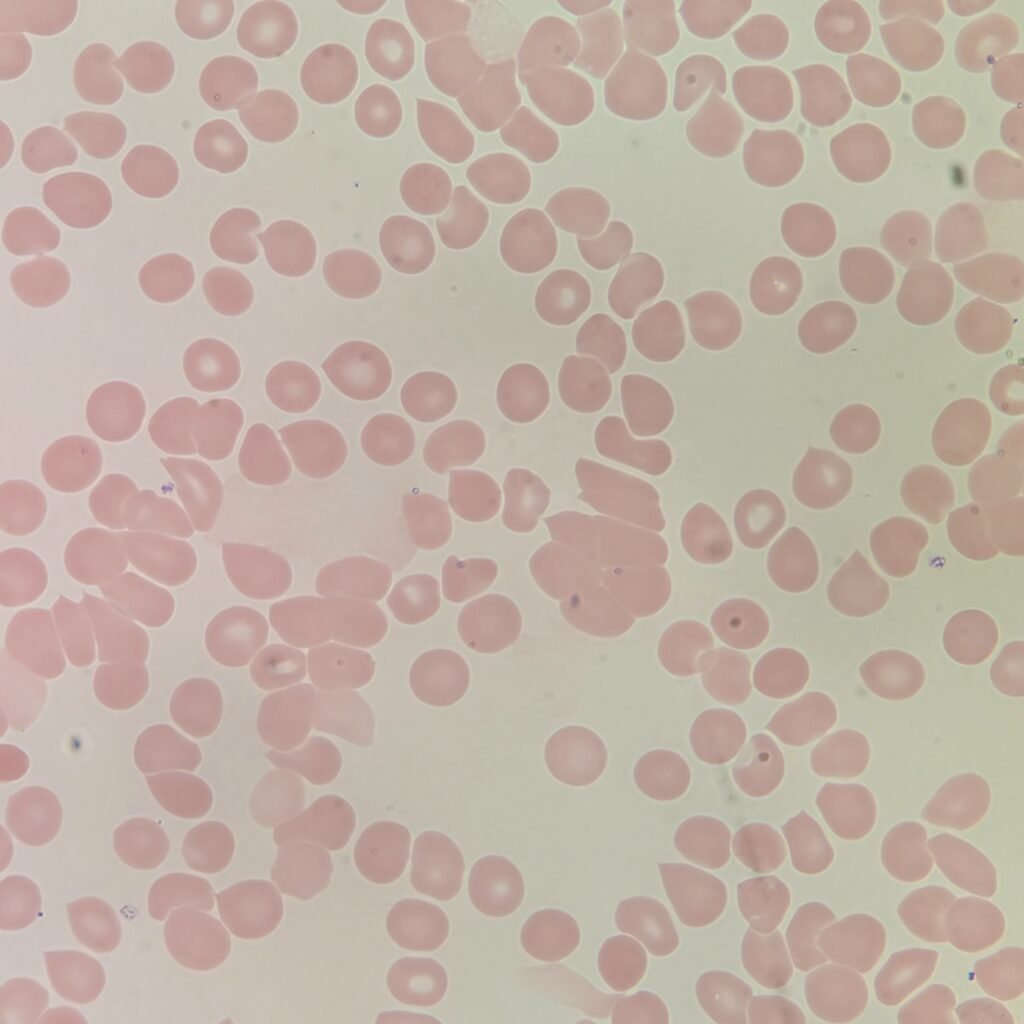
Red blood cells on a slide agglutinating/clumping together from a cold agglutinin.
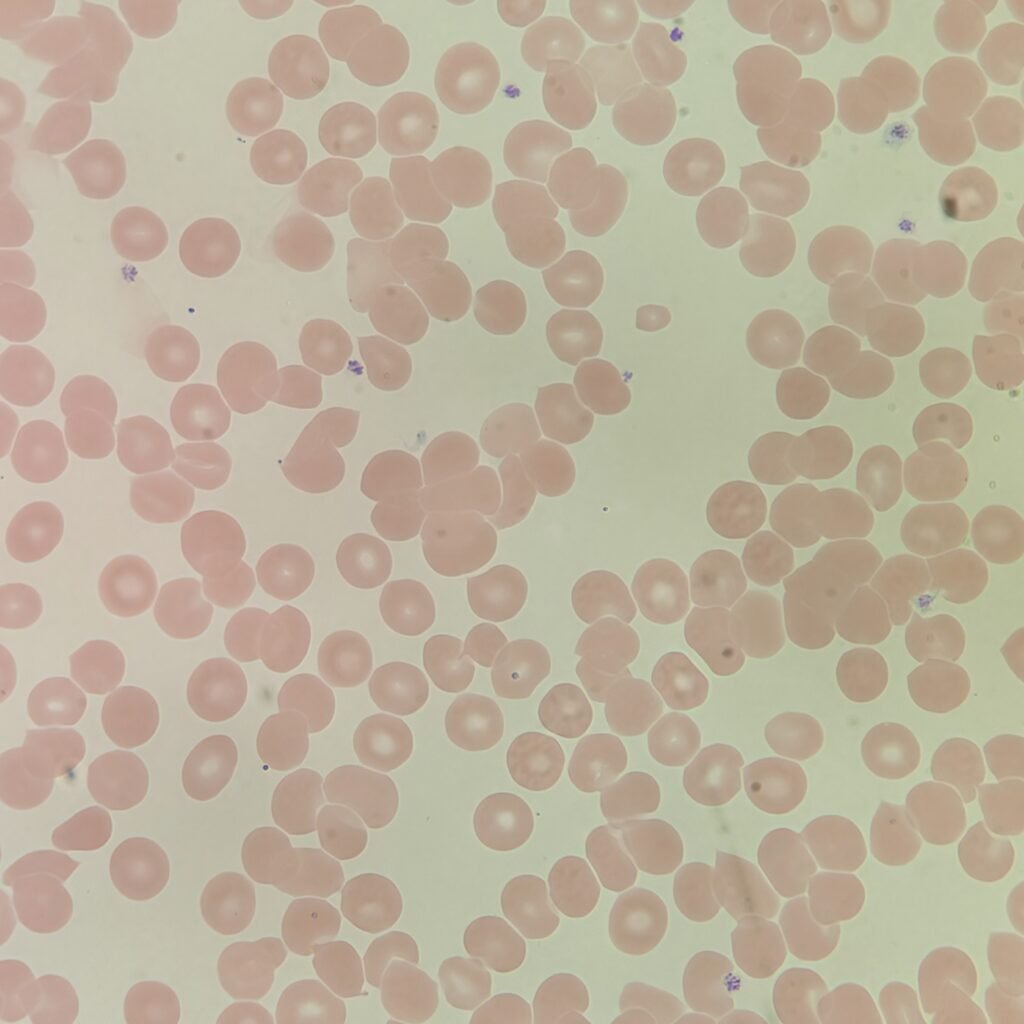
Red blood cells on a slide agglutinating/clumping together from a cold agglutinin.

Agglutination causes red blood cells to clump together. This can cause erroneous results such as increased Mean Cell Hemoglobin Volume (MCHC) and Mean Cell Volume (MCV) with a falsely decreased hematocrit. On the smear review, the red cells clumping together can hide other morphology.
Warming the specimen at 37 oC can help to resolve this issue, as it is usually caused by a cold autoagglutinin.
Macroscopic Appearance
Even macroscopically, the clumping can usually be seen on the slide. In this image, the left slide was prepared before warming the specimen while the right slide is after warming.

Microscopic Appearance
Agglutination causes red blood cells clump together even on thinner areas of the slide.

Lookalikes
Red blood cells also stick together in rouleaux. With rouleaux however, the cell stack linearly instead of in clumps.
Rouleaux

Gallery